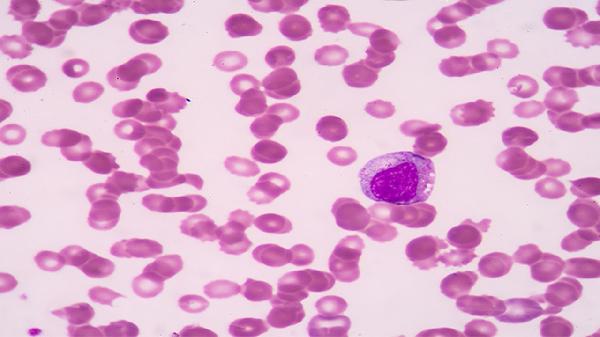
中性粒细胞百分比41.8怎么回事,怎么办

中性粒细胞百分比41.8怎么回事,怎么办
中性粒细胞百分比41.8可能由病毒感染、细菌感染早期、药物影响、血液系统疾病或免疫抑制状态引起,可通过抗感染治疗、药物调整、血液病干预等方式改善。

1、病毒感染:
病毒感染是导致中性粒细胞百分比降低的常见原因,如流感病毒、呼吸道合胞病毒等感染时,淋巴细胞比例相对增高。治疗以对症支持为主,部分病例需使用抗病毒药物,同时需监测血常规变化。
2、细菌感染早期:
某些细菌感染初期可能出现中性粒细胞暂时性降低,随着感染进展会转为升高。需结合C反应蛋白等炎症指标综合判断,必要时进行血培养检查,确诊后需针对性使用抗菌药物治疗。
3、药物影响:
部分抗生素、抗甲状腺药物、免疫抑制剂可能抑制骨髓造血功能。需详细询问用药史,必要时在医生指导下调整用药方案,定期复查血常规观察指标变化。

4、血液系统疾病:
再生障碍性贫血、骨髓增生异常综合征等疾病会导致中性粒细胞生成减少。需完善骨髓穿刺等检查,确诊后可能需要造血干细胞移植或免疫调节治疗。
5、免疫抑制状态:
艾滋病、长期使用糖皮质激素等情况会抑制中性粒细胞功能。需评估免疫功能状态,针对原发病进行治疗,必要时使用升白细胞药物改善指标。
日常应注意保持充足睡眠,每天保证7-8小时高质量睡眠有助于免疫系统恢复。饮食上多摄入富含优质蛋白的食物如鱼肉、豆制品,适量补充含铁丰富的动物肝脏和深色蔬菜。避免过度劳累和剧烈运动,可选择散步、太极拳等温和锻炼方式。保持居住环境通风,减少到人群密集场所活动以预防感染。定期复查血常规,如出现持续发热、乏力加重等症状应及时就医。